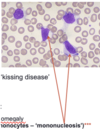

Theme 1- core microbiology Flashcards
(148 cards)
What are types of gram posive cocci?
Staphylococcus aureus
Streptococcus pyogenes
Streptococcus agalactie
What are types of gram negative cocci?
- Neisseria meningitidis
- Neisseria gonorrhoeae
What are types of gram positive bacilli (aerobes and anaerobes)?
- Bacillus anthracis
- Clostridium difficile
- Listeria monocytogenes
- Corynebacterium diptheriae
What are types of gram negative bacilli?
- Salmonella typhi
- Shigella spp
- Escherichia coli
- Proteus spp
- Yersinia pestis
What are types of gram negative coccobacilli?
- Haemophilus
- Bordetella
- Brucella
- Pasteurella
What are types of spiral bacteria?
Helicobacter
Campylobacter
Borrielia
Leptospira
Treponema pallidum
Do gram positive or negative cells have thick walls? What colour does each stain with?
Gram positive has a thicker cell wall than negative. Gram positive stain stains organism blue/ black is retained. Gram negative- fatty outer cell membrane which doesn’t retain the blue/black, then stained with counter stain that appears red.

Why do certain bacteria cause paticular infections?
- Host factors- Immune system and devices can cause colonisation
- Opportunity- exposure and normal flora
- Bacterial infections- environmental factors, virulence, resistance
Exposure to environmental or animal based pathogens.
Source of the infection is on you and what your normal flora is. Skin surrounding anus is colonisation of E. coli which is close urinary tract which can cause infection.
Where is E. coli found? Where is it able to adhere to?
- Part of normal bowel flora in most humans
- Colonisation of urethral meatus and surrounding area
- Short urethra in females
- Able to adhere to uroepithelial cells/urinary catheter materials
What does E. coli do?
- Triggers host inflammatory response
- Able to develop resistance to antibiotics
- Most common cause of UTIs
Where is S. aureus found?
Nasal carriage in up to 50% of people
Able to adhere to damaged skin
What does S. aureus do?
Produces exoenzymes and toxins that can damage tissues and provoke host response (e.g. pus formation)
What does Staphylococcus aureus cause?
- Causes skin/soft tissue infections – commonest cause, including of surgical site infections
- Bacteraemia/septicaemia
- Osteomyelitis/septic arthritis
- Endocarditis
- Pneumonia
- UTI
- Meningitis

Where is staphylococcus epidermis found?
- Opportunistic pathogen
- Skin commensal
- Most people will carry it on their skin
- One of 20+ species of ‘coagulase negative staphylococci’
What does staphylococcus epidermis adhere to?
Adheres to plastics/metals using glycocalyx (‘slime’), forming biofilms
What does staphylococcus epidermis cause?
Causes infection in association with ‘foreign bodies’ e.g. intravascular catheters, prosthetic joints, prosthetic cardiac valves, etc
What is the commonest cause of a sore throat?
Streptococcus pyogenes- Can also be referred to as ‘Group A Strep’
What does streptococcus pyogenes cause?
- Scarlet Fever
- Necrotising fasciitis (‘flesh eating bug’)
- Other SSTIs
- Invasive infections, such as pneumonia
- Puerperal sepsis- infection of genital tract in mothers that have given birth
- Also associated with secondary immunological presentations, such as glomerulonephritis

What is the commonest cause of bacterial pneumonia and menigitis (except in neonates)?
Streptococcus pnuemoniae
Can also cause other common childhood infections, such as otitis media

What is pneumonia?
Pneumonia is an infection that inflames the air sacs in one or both lungs. The air sacs may fill with fluid or pus (purulent material), causing cough with phlegm or pus, fever, chills, and difficulty breathing. A variety of organisms, including bacteria, viruses and fungi, can cause pneumonia.1
What does streptococcus agalactiae cause?
- Can also be referred to as ‘Group B strep’
- Commonest cause of bacterial meningitis and sepsis in neonates (babies aged under three months)
What is streptococcus milleri complex?
- Three closely related species of pus-forming streptococci
- Associated with abscesses: dental, lung, liver, brain and others

What is Viridans streptococci? Where are they found?
- Collective name for a number of species of α-haemolytic streptococci that inhabit the upper respiratory tract e.g. S. oralis, S. mitis
- Classic cause of sub-acute bacterial endocarditis
If you have heart valve from disease like aortic stenosis/ mitral regurgitation can lead to stasis of blood flow around valves allowing organisms to survive and adhere to the tissues leading to bacterial vegetation leading to bacterial endocarditis.
What is streptococcus gallolyticus? Where is it found?
- Formerly known as Streptococcus bovis
- A type of α- haemolytic streptococcus that forms part of bowel flora
- Bacteraemia with this organism can be associated with colonic malignancies